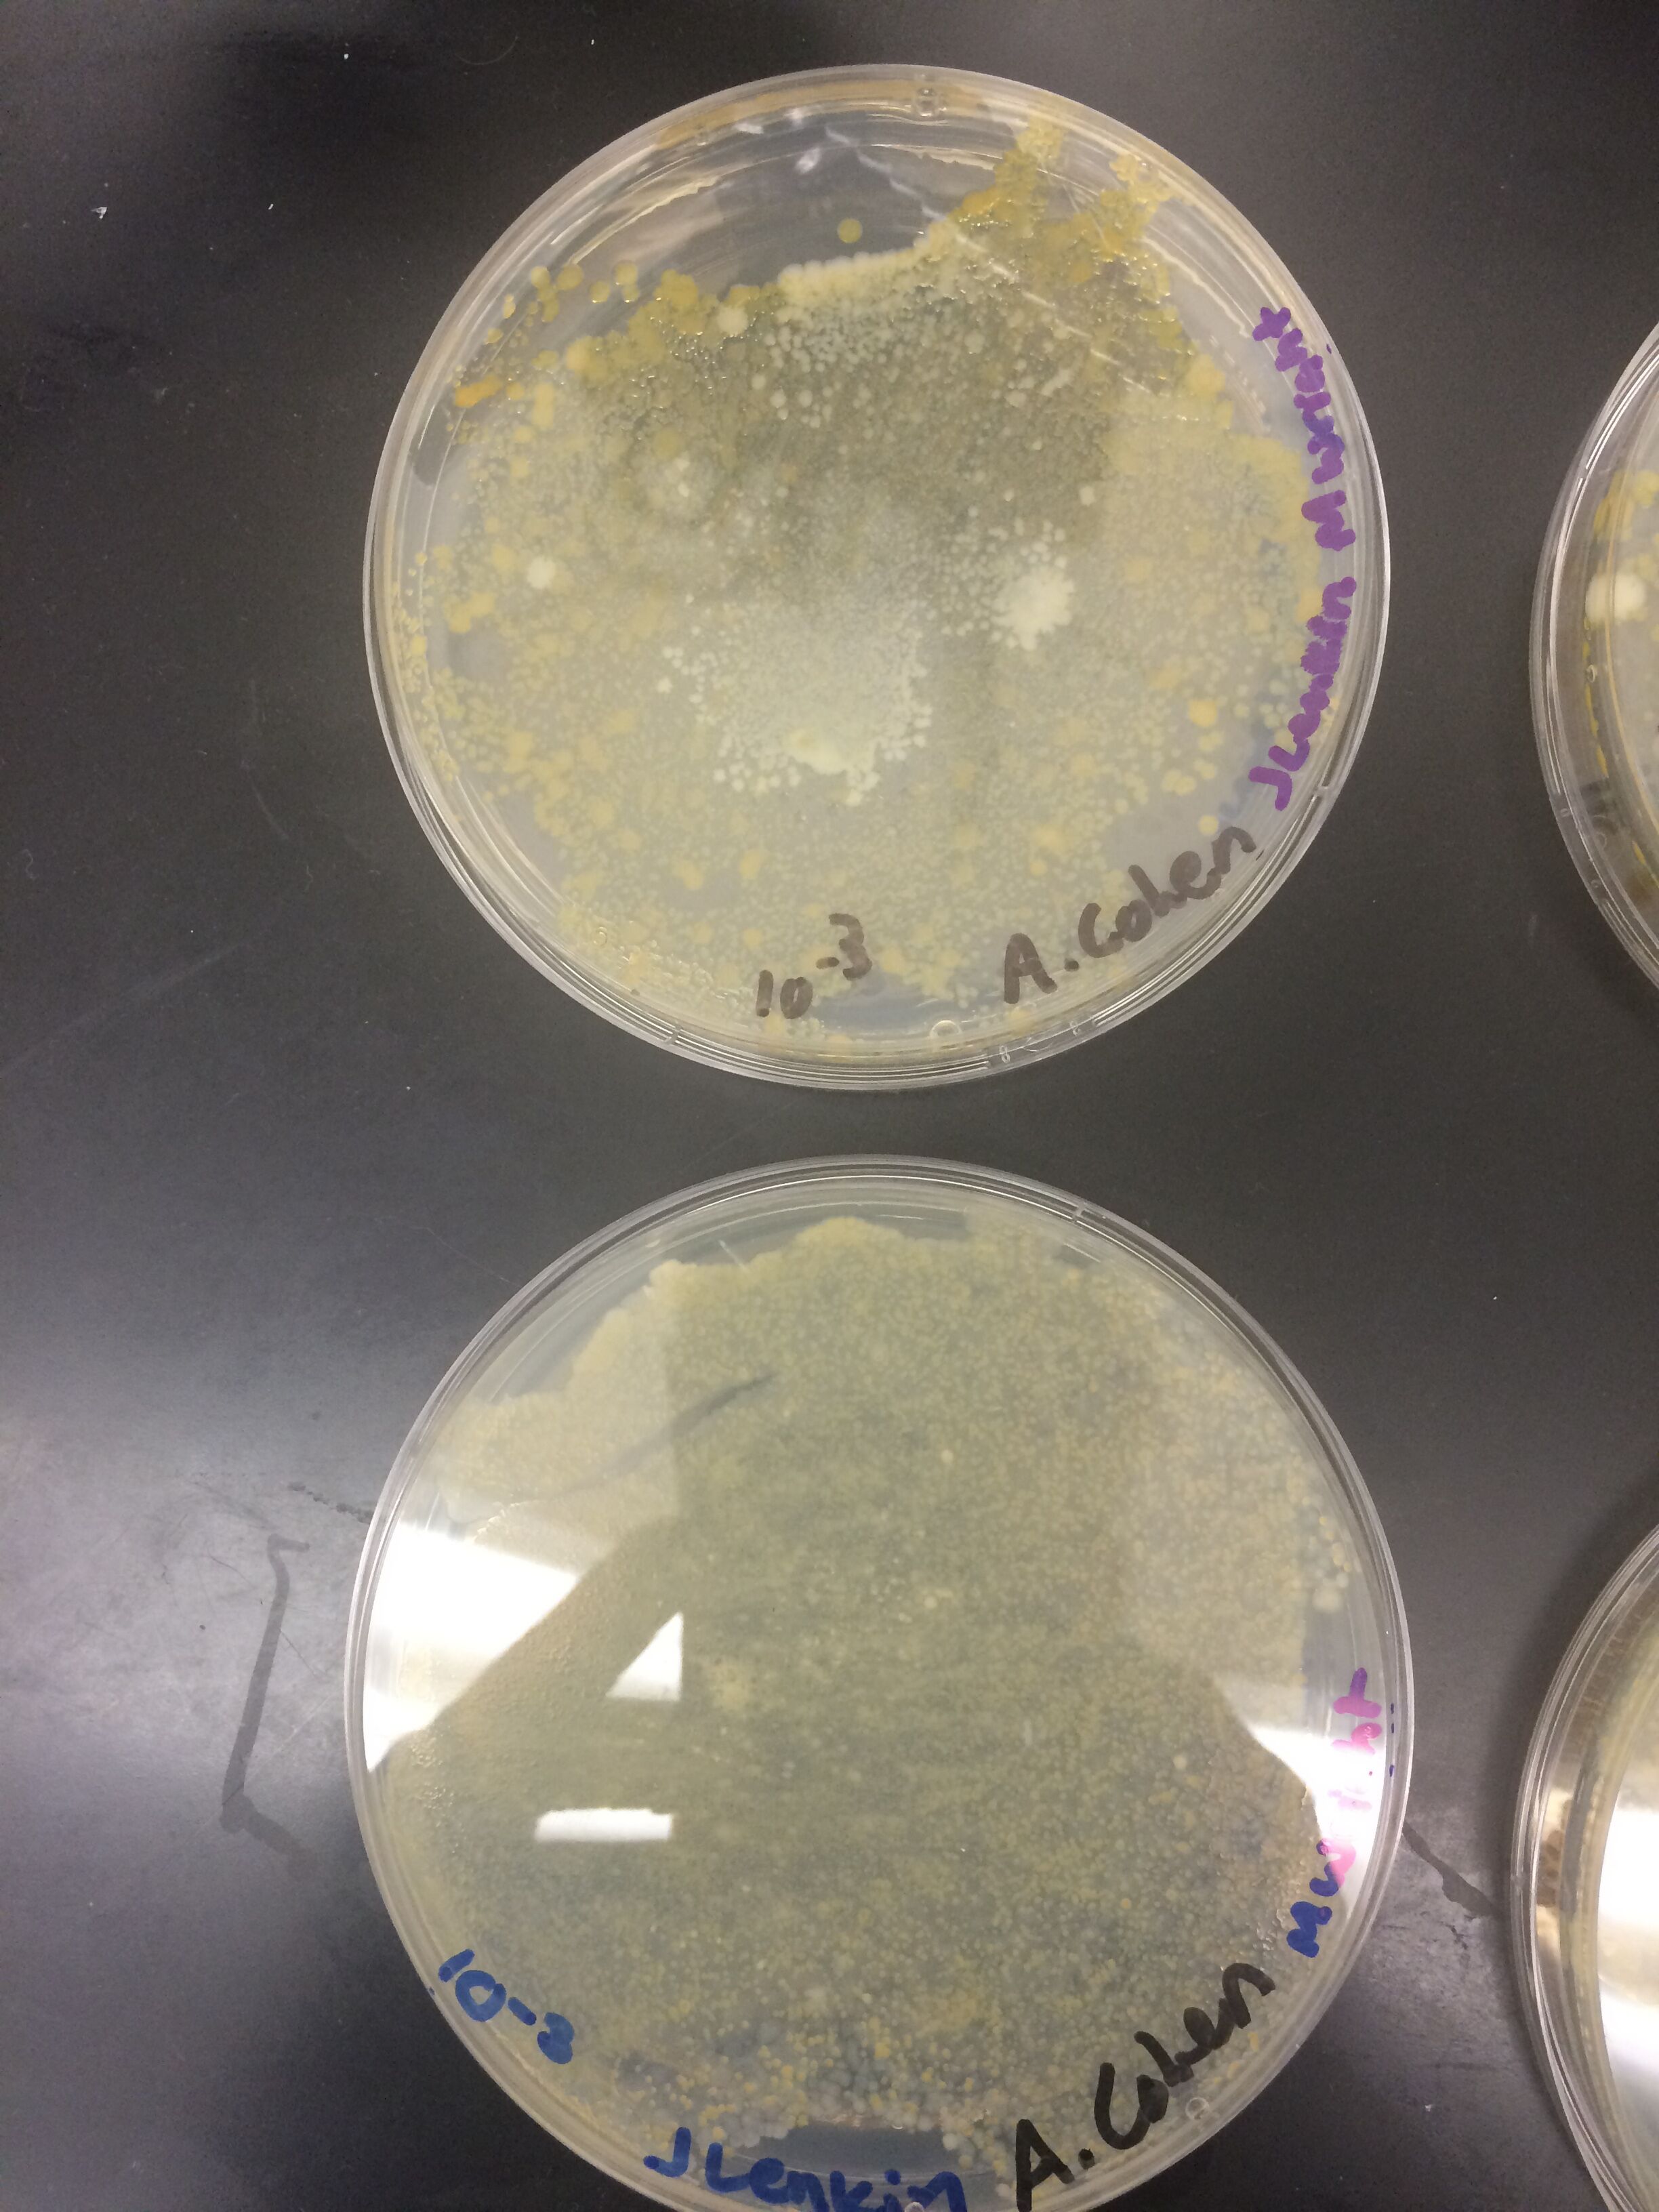
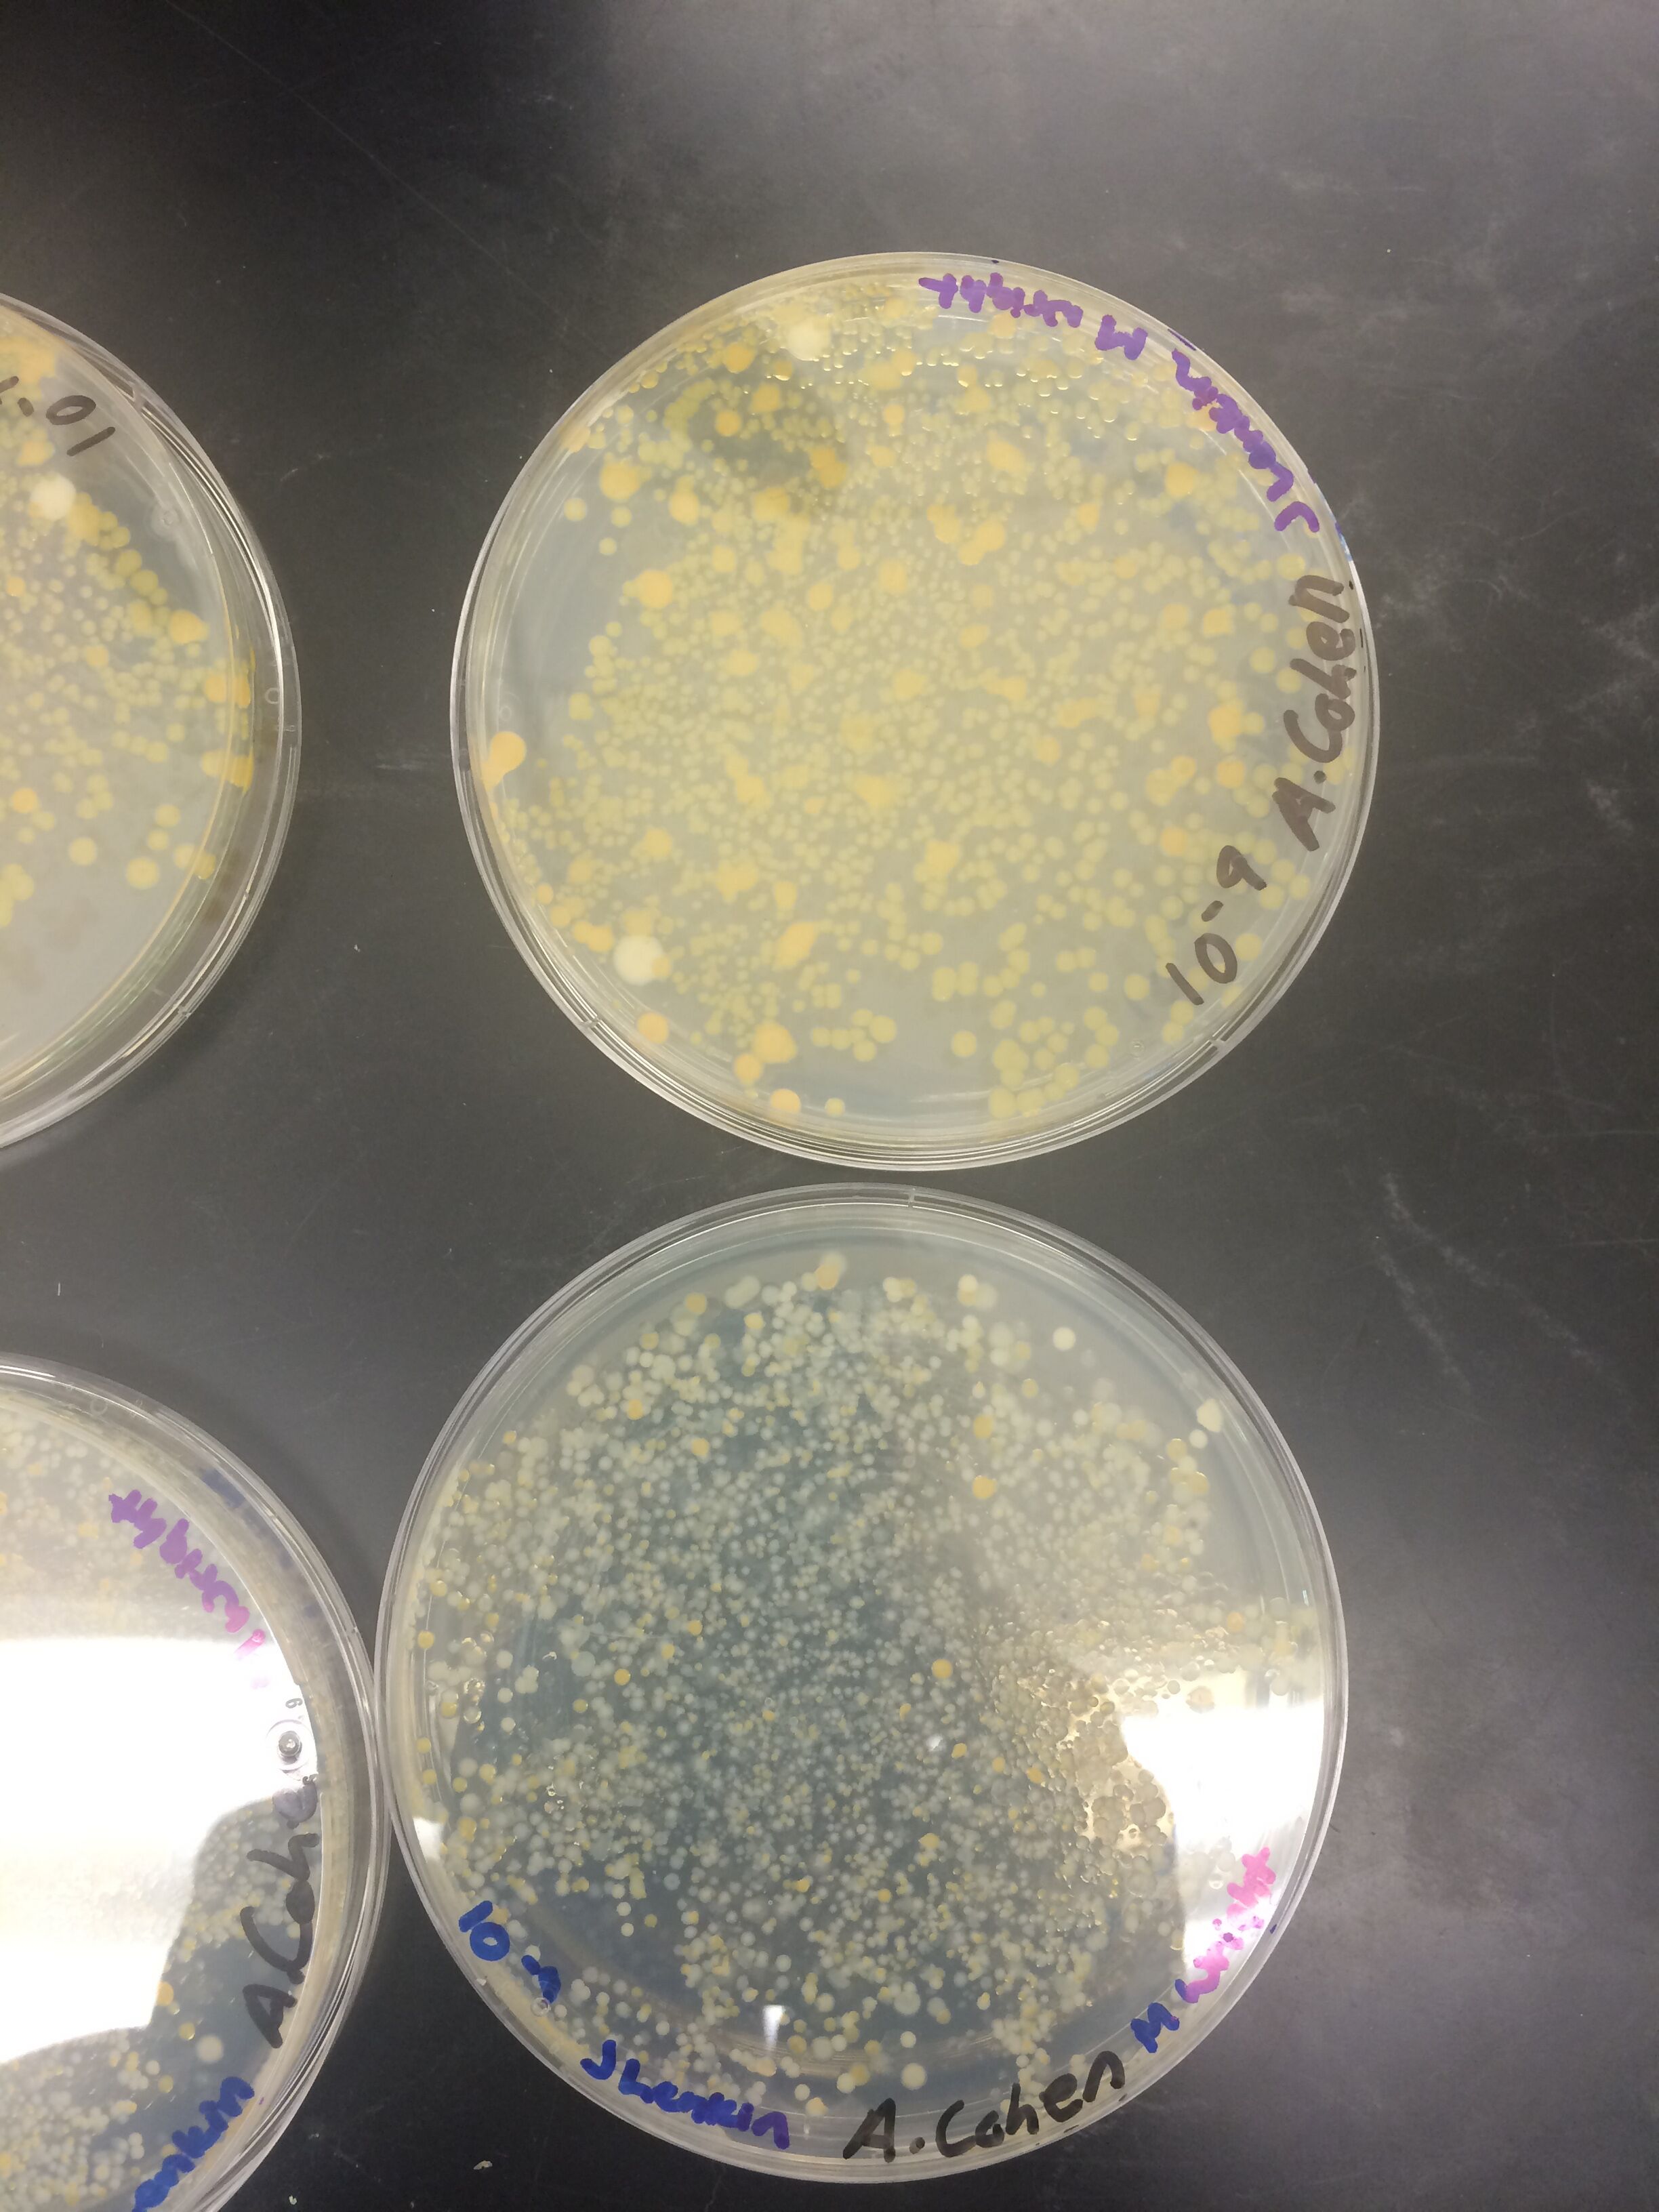

User:Austin Cohen/Notebook/Biology 210 at AU
Bio-Lab 210 Exercise 5: Invertebrates and Vertebrates 07/14/15 and 07/12/15
Introduction:
The goals of this exercise were to understand the role and evolution of invertebrate and vertebrate species, while also observing and identifying the ones in our transect. Invertebrates are crucial to learn about in order to study vertebrate species because it explains how the vertebrate species came to be. Invertebrates are very diverse, though the ones we mostly identified in lab were arthropods. This excercise required the group to collect invertebrates from the Burlese funnel experiment and identify them using an online resource or dichotomous key. It also required the group to return to the transect and observe the vertebrate species as well.
Methods:
The group began the exercise by taking the tube of the preservative from our Burlese Funnel experiment and collecting the invertebrate species that were gathered from it. The group put 10-15 mL of the liquid from the preservative and the invertebrate species on two small petri dishes in order to separate the invertebrates from excess material collected by the Burlese Funnel experiment. After completing this, we were able to identify the invertebrate species collected using a dichotomous key and online resources. After identifying the invertebrates, the group returned to the transect to make final observations about the larger animal species that lived there. After finding and identifying the animals that lived in our transect, a food web was created.
Results:
The identifications and characteristics of the invertebrate species are depicted by Table 1 below(top image). Note that in table 1, the bumble bees were included as invertebrate that we found in our transect, however, it was not collected in the Burlese Funnel. The identifications and characteristics of the larger animal vertabrate species are depicted by Table 2 (just below table 1). Below table 2 is an image of the petri dishes containing the invertebrates in our transect. Below the image of the petri dishes are pictures of three of our invertebrate species found in our transect. The food web is included below the images of the invertebrate species.
Discussion
Even though the group found that the transect did not contain a large amount of biodiversity, it did contain biological life that represents the concepts of "community", "carrying capacity", and "Trophic levels". In order to properly access the organisms in the transect as an accurate representation of these ecological concepts, the abiotic and biotic components of the transect have to be established. The abiotic components include, soil, air, sunlight, rocks, and water. The biotic components of all the living organisms benefit from these abiotic factors to continue the existence of this "community" of various populations of organisms. Rocks, for example, provide shelter or smaller niches for organisms, soil provides nutrients for plants, air allows animals to breathe, water is used by many organisms for various reasons, plants and bacteria use sunlight for photosynthesis, and there are many more uses for all of these abiotic factors as well. Our food web shows how our transect represents the concept of "trophic levels". For example, if you look at the food web (figure 1), the bottom rows show producers and nutrient providers for producers such as plants, dead animals, dead plants, dead leaves, bacteria and protists. As you go higher up on the food chain the trophic levels appear as it shows primary consumers like insects (bees, cedar beetles, earwigs, and pill bugs). The trophic levels continue to show when you look even higher up on the food web (at the top) to find the secondary/tertiary consumers such as animals (squirrels, sparrows, raccoons, and rats). It is apparent that the organisms in the transect also depict the concept of "carrying capacity" as well. The transect contains the necessities for a certain amount of these particular populations of species to exist in this ecosystem. One example of this are the rats who live in the transect. Rats mainly scavenge for nuts, vegetables, seeds and other food sources derived from vegetation. The area is clearly not flooded with these rats and it did not seem to be in the recent past either. This shows that there has been a maximum point in which the rat population of the transect has been limited to (at least in recent years). If there was no carrying capacity for the population of rats in the transect, there would be an extremely large abundance of these rats rather than a relatively equal amount. The previous evidence explains how the transect is an example of a functional ecosystem that represents the ecological concepts stated above. It also shows how the high biodiversity of an ecosystem is crucial for it to survive and thrive.
Bio-Lab 210 Exercise 4: Plantae and Fungi
07/09/15
Introduction:
This exercise required the group to return to our transect and observe the plants that are present there. Plants are very diverse and there are copious amounts of them throughout our transect that we were able to identify. Plants can vary in many ways including size, shape, vascularization, specialized structures, mechanisms of reproduction, and many more. Our goal in this lab was to identify, observe, and to compare and contrast the various plants we find in our transect. At the end of the lab we also set up the Berlese Funnel to collect invertebrates for the next lab.
Methods: The group began the lab by taking a Ziploc bag and going to our transect for observations, leaf litter, and plant samples. Once finished with gathering leaf litter and plant samples as well as observing our transect the group returned to the lab. In the lab the group attempted to identify the plants using phone applications and the internet. The group also made observations about each plant and recorded their characteristics, such as size, shape, vascularization, and specialized structures. The group also looked for evidence of reproduction mechanisms in each of the transect plants. After observing and identifying the transect plant samples we set up the Berlese Funnel to collect invertebrates. The set included the pouring of 50:50 ethanol and water solution into a 50 mL conical tube. The group then put a screening material at the bottom of the funnel and taped the sides of the screen to hold it in place in order to prevent leaf litter from falling into the preservative. We then carefully packed leaf litter into the funnel and set the funnel up on a ring stand which held it into the ethanol tube. We then used parafilm on the base of the tube so that ethanol would not evaporate. We then placed the whole set up underneath a 40 watt lighted lamp. The incandescent bulb was about 2 inches from the top of the leaf litter. The group then covered everything in foil and left it to collect invertebrates for the next lab class.
Results: The groups made observations about our transect and found that it contained mostly grassy plants without many flowers at first glance. The flowering plants were very small. After gathering 5 plants we brought them back to the lab to identify them and observe there characteristics more closely. The first plant we gathered is called a Broadleaf Plantain. The Broadleaf Plantain had a waxy leaf, was 5 inches in diameter, broad,round, and rigid shaped as well. It is a dicot and has the specialized structures of flowers, guard cells, and stomata. Its mechanism of reproduction is pollination and it is a flowering plant. The second plant is a white clover. This dicot had a three leaf structure and was about one inch in diameter. It contains the specialized structure of stomata, guard cells, and flowers. It is a flowering plant with the mechanisms of reproduction of pollination. The third plant is a Japanese Pagoda that is 10-15 ft high and has sparced narrow leaves. It is a dicot that has the specialized structure of having a trunk, flowers, stomata, and guard cells. Its mechanism of reproduction is seeds and pollination. The fourth plant is a false dandelion, which was about 4 inches in diameter containing narrow leaves close to the ground. This is another dicot containing the specialized structures of stomata, a waxy leaf, and guard cells. This flowering plant pollenates as well. The fifth plant is Crab grass. This is 1-6 inches tall and is a monocot. It has the specialized structure of guard cells, stomata, and a waxy leaf. Their mechanism of reproduction is through seeds and pollination. All of these characteristics are organized in the picture of table 1 below. The location of the plants are included in the picture of the transect map below as well. I have also included pictures of the plants when observing them in the transect as well.
Discussion In this the lab the group was successfully able to identify and characterize each of the plants we collected from our transects.Through this process the group was able to see the diversity of these plants and get a better understanding of how they function. The group can use this information about plants to understand how they are important. We can also connect it their function to improve the health of the environment that we live in by promoting the habitation of these plants. The group also noticed that there were many small organisms crawling around in our leaf litter sample which we will be able to observe in the next lab.
Bio-Lab 210 Exercise 3: Microbiology and Identifying Bacteria with DNA Sequence
07/07/15
Introduction: During this exercise the group set out to observe bacteria colonies we grew on agar plates, identify bacteria, and prepare a PCR test to amplify the 16s RNA gene. Our colonies were grown on nutrient agar plates in different dilutions. One set of 4 nutrient agar plates was treated with Tetracycline while the other set of 4 plates were not treated. Tetracycline is an antibiotic that prevents bacteria growth by inhibiting protein synthesis. This occurs when it prevents amino-acyl tRNA from attaching to the acceptor site of the ribosome (Chopra and Roberts 2001). Effects of Tetracycline work on bacteria including both gram positive and gram negative bacteria as well as Chlamydiae, Mycoplasma, and Rickettesiae (Chopra and Roberts 2001). In recent years bacteria resistance has sprouted and turned into a serious problem. The group aimed to make a connection between this antibiotic resistance issue and the colonies treated with tetracycline in the lab.
Methods:
The group started this lab by observing the growth of our Hay infusion cultures on the nutrient agar plates. When making these observations we kept a keen eye out for how the treatment with tetracycline effects the different cultures or specific types of bacteria. After observing the cell cultures the group performed a Gram stain procedure. This was done to separate the bacteria into their classification groups of gram-positive or gram-negative. From here we could make better observations of how specific bacteria is affected by the tetracycline. The group began the gram stain procedure by choosing four bacteria colonies (two treated with tetracycline and two untreated) to to undergo this procedure. One of the colonies from each group was white while the other was yellow (one yellow tetracycline treated colony, one white tetracycline treated colony, one yellow untreated colony, and one white untreated colony). After choosing the colonies we put each one on a slide with a drop of water on top of it. We labeled each slide saying whether it was treated with tetracycline or not. Then the group heat fixed the slides over a bunsen burner. After this, over a staining tray, crystal violet was used to cover the slides for one minute and then was washed off with a bottle filled with water. After this Gram's iodine mordant was used to cover the slides for one minute and then rinsed off with water. The group poured 95% alcohol on the slides for 10-20 seconds until the solvent appeared colorless. The smear on the slide was then covered with safranin stain for 20-30 seconds and then rinsed with water. The final step of this procedure was to wipe off excess water with kimwipes and let air dray for observation under a microscope. After the gram staining we took two cultures (one treated culture and one untreated culture) and put it in a tube with 100 micro liters of water in preparation for PCR next lab.
Results
When beginning the lab, by observing our hay infusion jar, we noticed that they had changed a lot in the last week. There was a much larger amount of a brown substance on the surface and at the bottom of our jar. The brown substance looked like moldy ground up algae stuck together and smelled moldy and rusty. When we first observed the colonies on the agar plates before Gram staining them we noticed that all of the colonies were circular colonies. The shapes of these colonies were also pretty even. The plates consisted of both yellow and white colonies, however there were mostly yellow colonies on the plates treated with tetracycline while the plates that were not treated had a much more even spread of each color. On the nutrient agar plates untreated, it was much more common to find that the colonies were grown in lawns and in extremely large amounts. In the plates that were treated there were fewer colonies and lawns were uncommon. So tetracycline resulted in less bacterial and fungal growth on the agar plates. The top picture below this paragraph shows our table one and our observation about these colonies. When observing the bacteria under a microscope after the Gram-staining procedure we were able to identify certain characteristics of individuals in the colonies we grew. The two colonies taken from the agar plate treated with tetracycline appeared very similar in size (~0.5-5 mm), motility (non-motile), shape (cocci), and arrangement (close together). The difference between these two colonies was that the yellow colony ended up having a pink color (Gram-positive) while the white colony was a brown color under the microscope (Gram-negative). The two untreated colonies were similar in size (0.5-3mm), motility (non-motile), shape (cocci), and arrangement (small separation yet still pretty dense). The difference between these two colonies after the gram stain was the the yellow colony ended being pink (Gram-positive) and the white colony was brown (Gram-negative). For both the treated and untreated samples the yellow colonies were Gram-positve, while the white colonies were Gram-negative. The pictures below show images of the bacteria under a microscope. Drawings of the observed bacteria are included as well (Figure 1 below shows the Gram-positive treated bacteria, figure 2 shows Gram negative treated bacteria, Figure 3 shows Gram-positive untreated bacteria, Figure 4 shows Gram-negative untreated bacteria). Note: Examples of the cultures on the agar plates prior to Gram-staining include the bottom 4 pictures.
Discussion:
In this lab we were able to observe how Gram-staining can separate bacteria into the Gram-Positive and Gram-negative bacteria as well as observing the effects of Tetracycline on our cultures. Through the Hay infusion lab, the group was able to make a clear connection of between the amount of bacteria on the agar plants and anti-biotic resistant genes. The next lab we will include PCR in our steps to fully understand what caused some of the bacteria to survive the Tetracycline treatment while others didn't and connect it back to the world issue of anti-biotic resistance.
References:
1) Chopra, I., & Roberts, M. (2001). Tetracycline Antibiotics: Mode of Action,
Applications, Molecular Biology, and Epidemiology of Bacterial Resistance.
Microbiology and Molecular Biology Reviews, 65(2), 232–260.
doi:10.1128/MMBR.65.2.232-260.2001
Bio-Lab 210 Exercise 2: Identifying Algae and Protists
07/2/15
Introduction:
Although algae and protists are very small, with the invention of the microscope we are able to observe and characterize these different organisms. Sometimes identifying them is a difficult task as well because of there small size, so a Dichotomous Key can be used. This key puts the observer of these small protists through a series of observations to guide them in their identification of the algae and protist.These can include observations about the size, shape, color, and movement Identification of protists is important for many reasons such as understanding the evolution of the organisms as well as their function in the ecosystem.
Methods:
First the group practiced using the Dichotomous key using a known sample. To do this we made a wet mount of a known organism and observed it under a microscope start at 4x and increasing to 100x. After following the steps given by the Dichotomous key we were able to identify many different organisms our known experiment. Before putting samples from our niche created in the Hay infusion from the previous week under a microscope to identify organisms in it, we made observations about it. The group then split up the niche in the jar into two different areas to take sample from. We took two samples from the surface of the top of the jar and two samples from the bottom of the jar which all included some plant matter. After this the group made a wet mount of the 4 different places within the niche and observed them under the microscope while using the Dichotomous key to identify organisms. After performing this we prepared our plates and serial dilutions (see key in results section).
Results:
Our hay infusion jar had a very strong dry odor that smelled moldy. There also appeared to be life in the jar as the top and bottom of it contained a brown moldy substance. The protists appeared to cluster around plant matter. This could be due to their scavenging for nutrients and it is present near the plant matter versus away from it. Some of them were motile while others were non-motile. The the two images below to the furthest top are photos of our jar used for the Hay Infusion. The picture to the bottom of those two photos is a drawing of what we saw in the microscope form the two samples. The next two to the bottom from that are the samples from the top of the Jar and then the next three are samples from the bottom of the jar. We were able to identify Parenema (30 micrometers) and Gonium (80 micrometers) from the top sample as well as Stentor Coeruleus (2 micrometers), colpidium (50 micrometers), and Spirostomum (2 micrometers) from the bottom sample. The image to the far right shows the procedure for preparing the plates and serial dilutions.
Discussion:
The group was successful in identifying the organisms in our Hay infusion culture. The organisms we found meet all of the need of life by the way that they are all made up of cells, they use energy, they pass down information, replicate as well as evolve to the niche we put them in. Because they can evolve if the Hay Infusion culture grew for another two months we would observe a large change in the types of organisms in the jar. Assuming that the jar is not left in the sun, non-photosynthesizing organisms would be more abundant than those that photosynthesize. This is an impactful selective pressure that could occur. The amount of organisms in the jar would also increase due to reproduction as well.
Bio-Lab 210 Exercise 1: The Transect and the Volvocine Line 06/30/15
Introduction:
The Transect used was a green lawn on the American university campus and rich in vegeation. Analyzing transects is very important in order to study the ecology around the American University Campus. The transects contains both biotic components, which are the living components, and abiotic components, which are the nonliving components. Both of these components are necessary for ecological research.
Methods:
In a group of four students, the 20x20 foot dimensions of the transect marked with four popsicle sticks was located. The transect was in between Hurst Hall and the East Quad Building on the side next to the the street, Nebraska Avenue (Map in results section). General characteristics, an aerial map with North, East, South, and West labeled, as well as a list of the biotic and abiotic components of the transect were created. A ground sample of soil was taken for the hay infusion. The group was careful to only take soil and leave out extraneous vegetation. The soil was then brought back to the lab to proceed with the hay infusion. In the lab we weighed and mixed 10 grams of the soil with 500 mL of Deerpark water in a plastic jar. 0.1 grams of dried milk was then added to the jar and then mixed, after putting on the lid, for 10 seconds. The jar was then labeled and placed with the lid off in a safe place in the lab.
Results:
The general characteristics that were observed about the transect was that there were many leaves on the ground, as well as a lot of green vegetation, the grass was not maintained and therefore very tall. It contained statues, lampposts, and sprinklers as well. There did not appear to be very much human interaction with the land. The group also listed the biotic and abiotic components of the transect. This included the biotic components of insects, trees, flowers, and fungi. It also included the abiotic components of sunlight, water, heat, air, rocks, and soil. The biotic and abiotic factors were all spread about the transect, but most of the biotic components were on the ground surface or in the soil. Below shows an aerial map of the transect as well as a few images of it.
Discussion:
This experiment included both the general observations of the transect as well as the preparation to do more specific studies on the ecology of it. We were successful in gathering this general information as well as prepare the hay infusion to set up our further studies in the next lab. Information about the ecology of our transect will be useful in assisting us in our interactions with land around campus as well as making us more aware of the health of our campus environment.